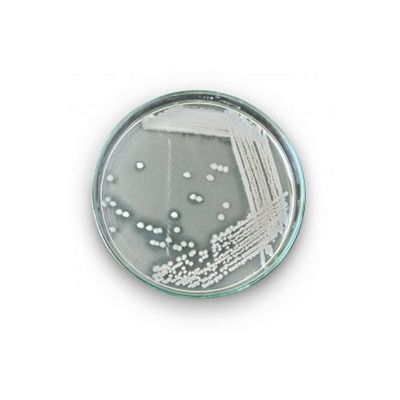

- Home
- Companies
- JBMbio.com
- Products
JBMbio.com products
JBMbio - Model DFM - Animal Direct Fed Microbials
Traditional animal feed ingredients are primarily produced from corn, cereals, and wheat, and although those components provide much-needed nutrients for the animal, they are difficult to completely digest. If ignored, undigested food can cause weight loss, diarrhea, decreased production of bile, over-production of stomach acid and even mortality.
JBMbio EnviroDEFENSE - Model ED 0401.1 - Enhanced Plant Growth
EnviroDEFENSE Enhanced Plant Growth (EPG™) is a probiotic for all green leafed plants with Plant Growth Promoting Rhizobacteria (PGPR). EPG is not a fertilizer - it just makes fertilizer more effective, delivering fertilizers and minerals to the plant, retaining more in the soil, and increasing nutrient uptake. EPG improves growth, vigor and tolerance to stress. Less fertilizer is lost as pollution - less can be used. Plants enjoy increased roots, foliage, bloom and yield. It helps protects plants from pathogens.
Animal Direct Fed Microbials (DFM)
Natural Bacteria Improves Digestion & Reduces Intestinal Imbalances. Traditional animal feed ingredients are primarily produced from corn, cereals, and wheat, and although those components provide much-needed nutrients for the animal, they are difficult to completely digest. If ignored, undigested food can cause weight loss, diarrhea, decreased production of bile, over-production of stomach acid and even mortality.
JBMbio - Model 0130.1 - Bacillus Coagulans
Bacillus coagulans is a type of good bacteria, also known as a probiotic. It produces lactic acid, but isn’t the same thing as Lactobacillus. Bacillus coagulans. The big advantage to a Bacillus coagulans is its ability to generate spores during its reproductive life cycle. This ability allows Bacillus coagulans to go dormant and survive harsh environmental conditions, which might kill off other probiotics.
Agricultural
EnviroDEFENSE - Model ED 0401.1​ - Enhanced Plant Growth
EnviroDEFENSE® Enhanced Plant Growth (EPG™) is a probiotic for all green leafed plants with Plant Growth Promoting Rhizobacteria (PGPR). EPG is not a fertilizer — it just makes fertilizer more effective, delivering fertilizers and minerals to the plant, retaining more in the soil, and increasing nutrient uptake. EPG improves growth, vigor and tolerance to stress. Less fertilizer is lost as pollution — less can be used. Plants enjoy increased roots, foliage, bloom and yield. It helps protects plants from pathogens.
Animal Waste Treatments
EnviroDEFENSE - Model ED 0208.1 - Animal Waste Degrader
EnviroDEFENSE® Animal Waste Degrader is a unique blend of multiple bacteria strains specifically formulated to effectively degrade dairy, rumen, swine, poultry and other commercially raised animal waste. EnviroDEFENSE® Animal Waste Degrader is an all-natural biological treatment utilizing powerful bacteria strains which have been carefully selected because of their ability to rapidly break down animal waste. EnviroDEFENSE® Animal Waste Degrader contains specific facultative bacteria which reduce solids, odors, and ammonia in stored waste.
Pond & Lake
EnviroDEFENSE - Model ED 0302.1 - PurPond Aquaculture
EnviroDEFENSE PurPond Aquaculture is designed for use in fish and prawn ponds, lakes and lagoons where organic odors and organic accumulations are a problem. Contains naturally occurring bacteria and enzymes, which have been selected and produced for their ability to break down organic matter and reduce ammonia accumulations through a natural oxidative process. EnviroDEFENSE PurPond Aquaculture digests these organics naturally and safely and keeps pond water fresh and disease free.